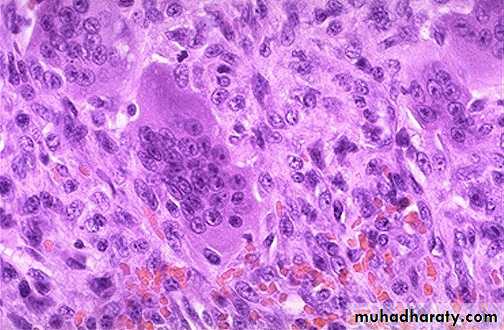

Osteopetrosis(marble bone disease ):
Group of uncommon hereditary disorder cause by deficient osteoclastic activity result in deposition of abnormally thick britle bone .Disease transmit as autosomal dominant &autosomal recessive .
Patient suffer from increase the incidence of fracture with features of anaemia , thrombocytopenia , & leucopenia due to reduction in bone marrow space .
Osteomylitis :
Pyogenic (acute )osteomylitis :Usually due to bacteria (mainly staph.aureus , less commonly due to E.coli , Pnumococci & group B –streptococci )& rarely due to fungi .infection reach the bone by :
* hematogenous spread involve long bone & seen in children.
* direct spread involve jaw & skull & seen in adult.
* as a complication of compound fracture , prosthesis , debilitation & immunosuppressant .
Complication :
- septicemia .
- acute bacterial arthritis .
- Pathological fracture .
- Chronic osteomylitis.
- vertebral osteomylitis may cause para vertebral abscess & vertebral collapse .
Chronic osteomylitis :.
Tuberculous osteomylitis :
Rare in developed countries but still common in developing countries .
Seen in adolescent & young adult involve the spine & long bones .
Complications :
1- Multiple discharge sinus as in lumber cold abscess .
2- T.B of vertebrae ( potts disease ) cause compression fracture & disc destruction result in paraplegia .
3-extension of pus from lumber vertebra cause psoas abscess .
4- secondary amyloidosis.
Osteoporosis :
Group of disorder characterized by reduction in bone mass & density associated with increase the risk of fracture pain & deformity .affect post menopause female mainly , radiological diagnosis appear if 30% of bone mass is lost ,serum calcium , serum phosphorous & alkaline phosphatase are normal.
Causes ( types ) :
1-primary ; include idiopathic , senile & post menopausal .
Secondary :
a- endocrine : hyperparathyroidism ,hyperthyroidism , cushing syndrome ,D.M type 1.
b- Tumors :Multiple myeloma , mast cell disease ,carcinomatosis.
c-GIT :malnutrition , malabsorption , VD &VC deficiency .
d-drug : anticoagulant , steroid , chemotherapy.
e- Miscellaneous : immobilization , cardiac & pulmonary disease.
Pathogenesis :
It is due to decrease bone formation accompany in post menopause women by increase bone resoption due to decrease estrogen level .
R : isk factors include age , sex , genetic , hormone deficiency( estrogen & androgen )& nutrition state .
Role of Estrogen deficiency :
1-it inhibit the production of osteoprotegrin so it stimulate the formation of osteoclast from macrophage .2- it increase the level of IL-1 & TNF both stimulate the formation of RANK ligand & macrophage CSF both stimulate the formation of osteoclast .
In early state the disease is asymptomatic & diagnose by DEXA (dual energy x-ray absorption) While in advance stage it can diagnosed by routine x- ray .
Osteitis fibrosacystica :
Hyperparathyroidism (primary or secondary to renal disease ) cause increase in osteoclastic resoption of bone by :
1-Increase production of RANK ligand by osteoblast so more esteoclast form .
2- increase calcium re absorption by kidney .
3-increase synthesis of active VD by kidney which increase absorption of calcium by gut .
So excess parathyroid hormone cause hypercalcimia , hypophosphatemia &hypercalciuria .
Mic :
Increase number of osteoclast accompany by erosion of bone surface &marrow space show fibrovascular tissue containing haemosidrin laden macrophage with osteoclast & giant cell producing brown tumor of hyper parathyroidism .
Ricket & osteomalacia :
They cause defect in bone mineralization result in increase non mineralize osteoid tissue seen in children & adult respectively .in contrast to osteoporosis in which total bone mass is reduce but with normal mineral content .Paget disease ( osteitisdeformans ) :
It is osteolytic & osteosclerotic bone disease of uncertain origin involve either one bone ( monostotic) or several bone (polystotic) . the disease pass into 3 stages :
1-initial osteoclastic phase ,
2-mixed osteoclastic & osteoblasticphase .
3-osteosclerotic phase characterized by formation of dense mineralized bone with minimal cellular activity .
It is uncommon before the age of 50.associated with normal to high serum calcium & osteosacoma is uncommon complication seen in 1% of cases .
Fibrous dysplasia : benign tumor like condition in which bone trabecula is replace by fibrous tissue with island of mal formed bone .It has 3 pattern :
1-involve single bone (monostotic ).
2-involve multiple bone ( polystotic).
3-polystotic with endocrine abnormality .
Bone tumors :
Secondary tumors ; commoner than primary malignant tumours.
* The primary sites in descending orders are prostate , breast , lung , kidney , GIT & thyroid .
* The lesion usually osteolytictype , it may be mix type (osteolytic&osteoblastic ) while in prostatic carcinoma it is of osteoblastic type .
Primary bone tumors :
1-Bone forming tumors :a-Osteoma :
*benign lesion seen mainly in head &neck .
* present as solitary hard ,exophytic growth attach to the surface of bone .
* it may be multiple as in gardener syndrome .
Mic : mixture of woven & lamellar bone difficult to distinguish from normal bone .
b-osteoid osteoms .
c-osteoblastoma.
Both are similar tumors but differentiate in their site , size .osteoid osteoma occur in proximal femur & tibia , smaller than 2 cm , local pain which relieve by aspirin is the main symptom .
Osteoblastoma occur in vertebra , larger than 2 cm ,cause pain which is not localize & not relieve by aspirin .
Mic :
Compose of woven bone trabeculae surround by osteoclast , the intervening stroma compose of loose vascular C.T instead of marrow element & contain variable number of giant cells.
d- Osteosarcoma :
Excluding multiple myeloma it is the most common primary malignant tumors.*either primary (arise Denovo) or secondary complicate paget disease , radiation rarely complicate fibrous dysplasia ,osteomylitis.
*Primary type occur during 2nddecade ,.
* arise in the metaphysic of long bones especially around the knee (lower femur & upper tibia., it is aggressive lesion usually metastases to lung .
* It start from the cortex extend outward to the soft tissue elevating the periostium producing Codman triangle on X-ray .
* Formation of osteoid tissue by malignant mesenchymal cell is diagnostic (osteoblastic type ).
Secondary type occur in older age ,, it is aggressive tumour but less response to treatment than primary.
2-Cartilagenous tumor:
a-osteochondroma :Benign bone tumor compose of mature bone cover by cap of cartilage. Usually solitary & sporadic rarely multiple as in multiple hereditary exostosis
.
b-chondroma (enchondroma) :
benign tumor compose of hyaline cartilage , occur at any age ,usually single seen in small bone , may be multiple as in Osler disease & Maffucci syndrome , both show cellular atypia .c- Chondrosarcoma :
second most common non hemopoietic bone tumor after osteosarcoma , affect old age after sixty , seen in axial bone (pelvis ,shoulder & vertebrae ), usually arise denove or may complicate osteochondroma or enchondroma , compose of malignant mesenchymal cell that produce cartilage .
3- Other tumors :
a- gaint cell tumor (osteoclastoma ) :
Benign tumor of bone , compose of large number of osteoclast mix with mononuclear neoplastic cells .Seen in epiphysis of long bone so may mistake with arthritis .
Multicentricity is uncommon & when present it raise the possibility of hyperparathyroidism .recurrence is common after resection , but malignant change is rare.
b- Ewing sarcoma
*Second most common bone tumor in children after osteosarcoma.*Affect children &adolescent .
*femur ,tibia & pelvis are the favorable sites .it start in the medullary cavity at diaphysis then extend into cortex & periosteum where it deposit bone lamella in an onion skin pattern .
Mic : it consist of sheets of blue cells with uniform nucleus & scanty cytoplasm & it should differentiate from other blue cell like NHL , neuroblastoma
&rhabdomyosarcoma .
-